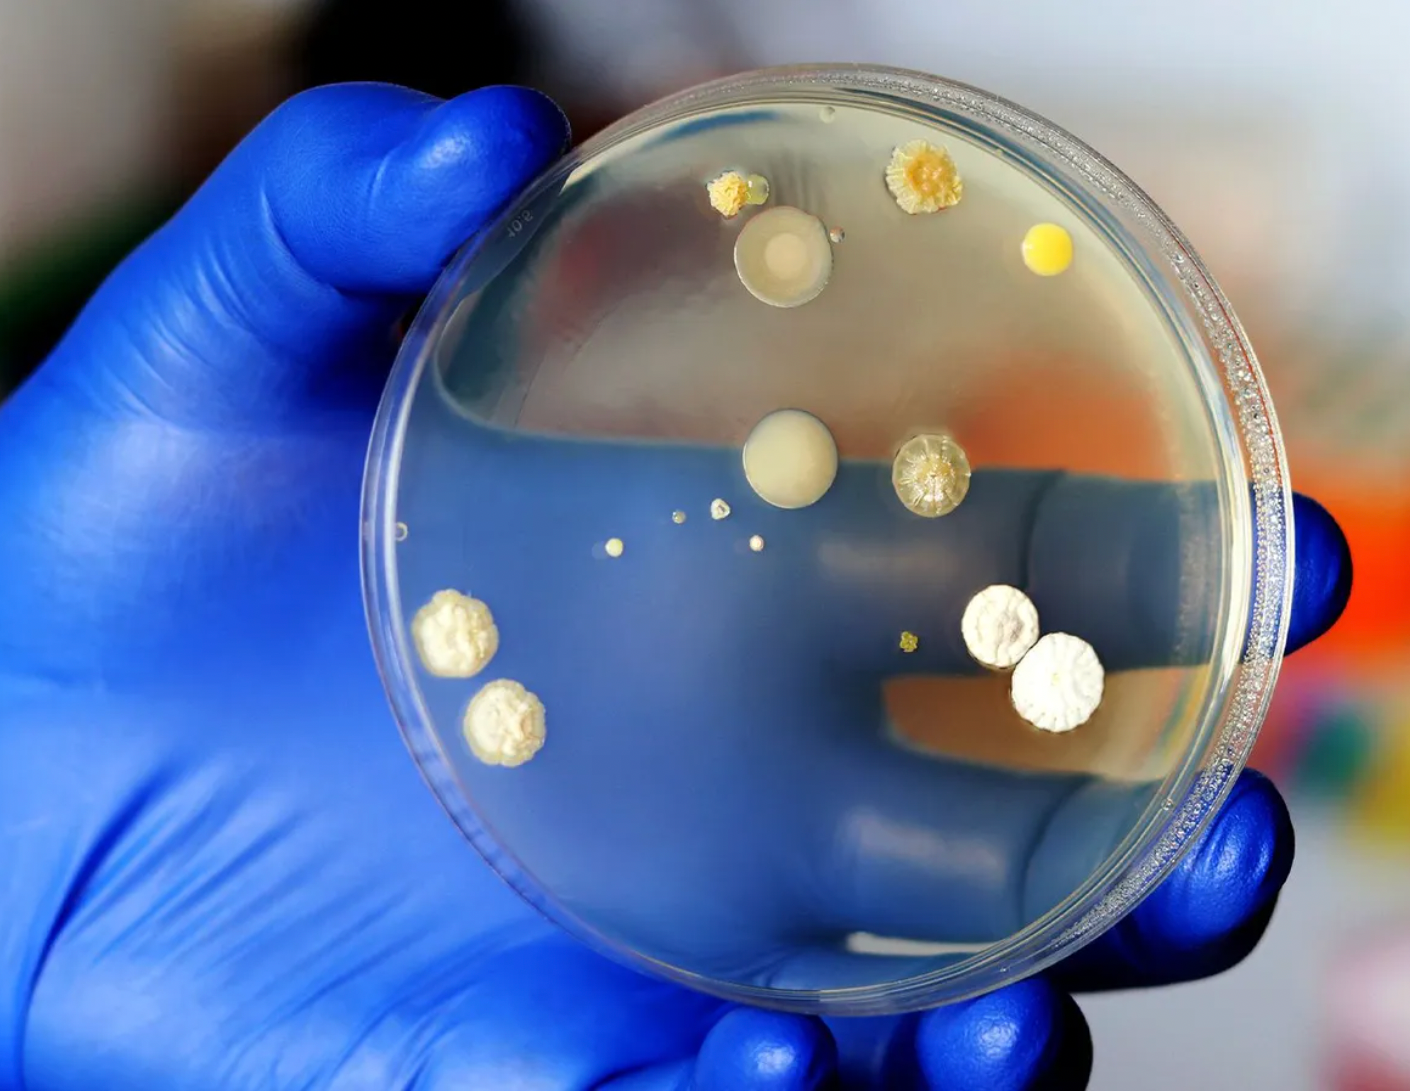
Alt Image

Ingredients
Frequently asked questions
What is the return policy?
Our goal is for every customer to be totally satisfied with their purchase. If this isn't the case and you aren't satisfied with your product, we offer free returns within 60 days of purchase.
How long will my ClearRest bottle last?
On average, the bottle will last you between 6-8 weeks.
When will I get my order?
We will work quickly to ship your order as soon as possible. Once your order has shipped, you will receive an email with further information. Delivery times vary depending on your location. However, the average shipping time is 3-7 Buisness days.
Where are your products manufactured?
Our products are manufactured both locally and globally. We carefully select our manufacturing partners to ensure our products are high quality and a fair value.
How much does shipping cost?
Shipping is calculated based on your location and the items in your order. You will always know the shipping price before you purchase.
But the maximum price you will be charged for shipping is 7$